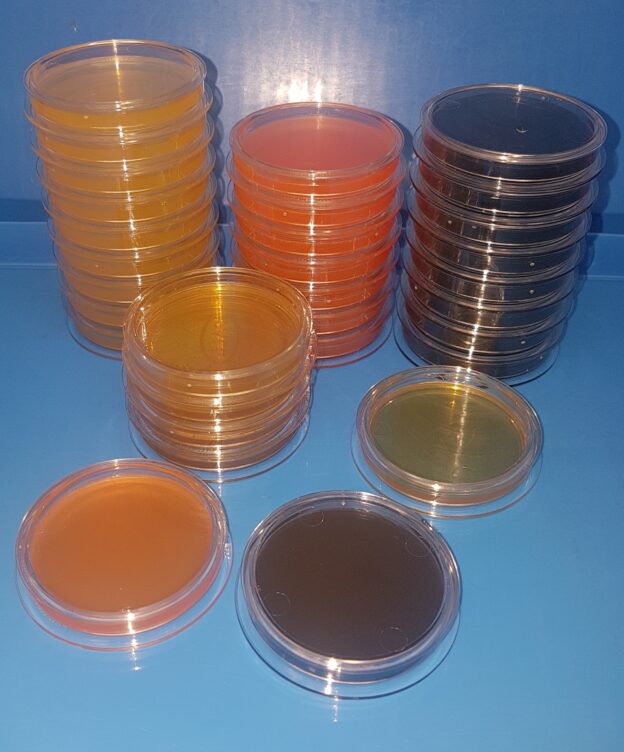

Placas preparadas para Filtración de Membrana: Plaquis® Herméticas, donde el agar no se retrae ni se seca, larga caducidad; y apilables.
Presentamos las plaquitas herméticas de 47 mm de diámetro, especiales para filtración de membrana, la cual cabe exacta colocándola contra la pared.
Y también muy útiles para estría tras enriquecimiento de patógenos.
Ventajas de las Placas preparadas para Filtración de Membrana en formato «PLAQUIS® de MICROKIT®»:
♥ Enorme caducidad real, no ficticia: mínimo 4 meses si se conservan con variaciones de temperatura día/noche y 6 meses (o incluso más) si se conservan a temperatura constante
Ahórrese el disgusto de las otras plaquitas de filtración, que se retraen y secan mucho antes de la fecha de caducidad indicada por sus fabricantes
♣ Ocupan menos espacio que las de 60 mm (y por supuesto que las de 90 mm) en almacén, estufas y residuos
♦ No necesitan transporte ni almacén refrigerados: se conservan ideal a 16 ± 5 ºC (sí, su temperatura ideal de conservación es de 11 a 21 ºC), eso sí, en oscuridad como todo medio preparado
♠ Se pueden apilar en columnas altísimas en la cabina y estufa sin que se desmoronen, gracias a su diseño de encaje perfecto
♥ Mucho menos plástico que contamina el medio ambiente por cada ensayo, que las placas y plaquitas convencionales
♣ Cámara de aire validada tanto para fermentadores como para «super-aerobios», en función del volumen del medio de cultivo dispensado
♦ Plaquis® preparadas de todos los medios de aguas de consumo, envasadas, refrescos, vino y cerveza: CCA, SB, BEA, EPA, CN, YEA, R2A, Maxim-PCA cromogénico, Standard TTC, Sabouraud Caf, Rapid RYM, WL, M-Green, Brettanomyces…
♥ Y tambien de todos los medios para estríar tras enriquecimiento: Salmonella ABC, XLD, Listeria O&A, Baird Parker, BPX19, BCPT, BCSA, Biggy, Cetrimida, CUP12A, EMB Levine, KIng A/B, MacConkey Agar, mFC, RB Caf…
Sin duda, el formato más cómodo del medio preparado
https://www.microkit.es/pdf/plaquis.pdf
Para más información, contacte con nosotros en microkit@microkit.es